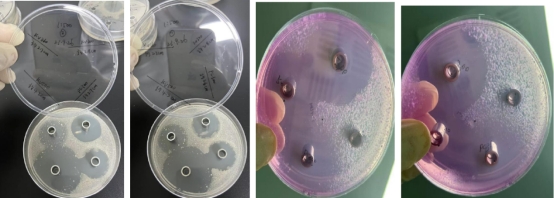
新闻图片3

微信扫一扫
关注公众号
硫酸葡聚糖500,000
¥660 - 12430
产品分类
- 酶及底物 (520)
- 免疫学 (3087)
- 标准品/对照品 (536)
- 生物制药与疫苗 (604)
- 分离纯化 (37)
- 生化试剂 (28748)
- 分子生物学 (21)
- WAKO (13608)
- Jackson ImmunoResearch (2012)
- Ludger 糖链分析 (87)
- Lumiprobe活性染料 (3)
- abcam (39100)
- Merck-Sigma (44401)
- MP Bio (11006)
- 试剂 (9706)
- 健康原料 (24)
- 新型材料 (345)
- 仪器分析 (1025)
- 合作品牌 (44464)
- Aalto
- AAT Bioquest
- AbD
- Active Motif
- Advanced Targeting Systems
- Ambion
- AnaSpec
- AssayDesign
- Avanti
- Bangs Laboratories
- BioPorto
- BioSource
- bioworld
- cayman
- Chemicon
- Clontech
- CST
- DiFco
- Epigentek
- hampton
- Himedia
- Hyclone
- ldmsapp
- Innova Biosciences
- Invent
- J.T.BAKER
- KPL
- lifespan
- MRC
- Phytotech
- Pierce
- Prozyme
- Qiagen
- R&D
- Roche
- Santa Cruz
- Vector
- Worthington
- 其他分类 (9)
服务保证
西宝风采
公司新闻
Krovin 500长效广谱防霉抗菌剂
发布时间:2023-10-08 09:01 | 点击次数:1176
随着体外诊断技术的不断创新,我国体外诊断试剂行业获得快速发展,相关产品更是日新月异,不断升级。在配制各种液体试剂或液体制剂中。特别是体外诊断试剂的研发、生产过程中,除准确性和重复性外,同样需保证产品的良好适用性和品质,且低毒高效、通用性广、生态环境友好。
在体外诊断试剂行业中,杀菌抑菌等防腐剂的选择至关重要,决定体外诊断试剂质量的好坏。西宝生物十多年作为生物试剂原料专业服务商,一直致力于提供长效、广谱、高效、低毒、环保的防腐剂。自主开发的新型无毒环保体外诊断试剂专用防腐剂KroVin500 (KV500),可替代传统的NaN3、硫柳汞等对人体及环境毒害大的防腐剂产品。详情咨询400-021-8158或访问我司网站www.seebio.cn.
KroVin?500防腐剂(活性成份为α-巯基-N-氧化物>20%水溶液)
作用机理
KroVin500生物防腐剂作为离子载体,可穿过细菌的细胞膜,将质子运入细胞,携带钾离子离去,经过反复穿梭破坏了细胞膜两边的离子梯度,使细胞膜不能运输养分而导致细胞死亡。
在此过程中,KroVin500自身并没有消耗,故能持续发挥作用。
产品特点
- 防霉抗菌效果佳:本品对黑曲霉、黄曲霉、变色曲霉、桔青霉、宛氏拟青霉、绿色木霉、球毛壳霉、腊叶芽枝霉等显示出较好的霉菌防霉抗菌效果。
- 细菌抗菌效果优秀:本品对大肠杆菌、金黄色葡萄王求菌、桔草芽胞杆菌、巨大芽孢杆菌、荧光假单胞杆菌等细菌均显示出优秀的抑杀效果。
- 酵母抗菌效果良好:本品对酒精酵母、啤酒酵母等多种酵母菌均显示出良好的抑杀效果。
- 安全性高:对小鼠急性经口LD50>1000mg/kg;对皮肤无刺激性;三致试验阴性。
- 溶剂相溶性:易溶于水,在pH5-11范围内都有效;特别适合在碱性和中性条件下稳定,酸性条件下效果略有下降。
- 广谱、长效,替代传统的防腐剂:NaN3、硫柳汞等对人体及环境毒害大的产品。
- 它与重金属离子能发生螯合反应(可中和重金属离子对产品或配液体系干扰)。
质量指标:
|
Active principle
|
40.0%~41.0%
|
|
Density
|
1.10~1.3 g/ml
|
|
pH
|
9.0~11.0
|
|
Shape and properties
|
Light yellow liquid
|
应用领域
KroVin 500系列防腐剂pH耐受适用范围广,pH 5~11(最适PH6.5~10.5),化学稳定性好,可与水及阴离子、阳离子、非离子等各种离子型乳化剂、表面活性剂以及血清、蛋白质、酶等配伍。
适用比例:0.05~0.2%;具体根据样本体系确定,必要时可提高浓度。也可与KroVin300、KroVin360混合使用,效果更好。
主要有以下应用:
1)对照品、包被液、封闭液、稳定液、稀释液、缓冲液;
2)血气分析、血球试剂、稀释液等;
3)校准液(pH等);
4)清洗液和容器、管道、水槽等清洗和消杀抑菌;
5)体外诊断试剂盒和试剂配制。
6) 也可配制消毒剂、洗洁剂和广谱抗真菌皮肤科用药等产品。
1)对照品、包被液、封闭液、稳定液、稀释液、缓冲液;
2)血气分析、血球试剂、稀释液等;
3)校准液(pH等);
4)清洗液和容器、管道、水槽等清洗和消杀抑菌;
5)体外诊断试剂盒和试剂配制。
6) 也可配制消毒剂、洗洁剂和广谱抗真菌皮肤科用药等产品。
包装储存
本品包装规格为25ml、100ml、500ml、5L。在正常室温储存情况下,可稳定储存二年。储存期内,如发现沉淀物,使用前混合均匀,不影响其杀菌效果。
注意事项
1、本品虽然低毒、使用安全,但仍需避免接触嘴巴、眼睛和皮肤。操作时请做好防护工作。
2、请于避光阴凉处贮存。
3、本品与一些氧化剂不相容,如过酸盐、亚硫酸盐等。对光、氧化剂和强还原剂不稳定。非离子表面活性剂会微弱影响(可适当加大用量),它与重金属离子能发生螯合反应(可中和重金属离子对产品或配液体系干扰)。
4、使用时温度不要超过45℃。
Seebio更多防腐剂系列应用领域
|
应用
产品系列
|
PH适用范围
|
免疫层析、胶体金
|
酶联免疫、化学发光
|
生化
|
血气分析 血球
|
仪器设备管道清洗消毒
|
||
|
对照品
|
样本
稀释液 |
酶标
稀释液 |
||||||
|
KroVin 100
|
|
|
|
|
|
☆
|
|
☆
|
|
KroVin 200
|
3-9.5
|
☆
|
☆
|
☆
|
☆
|
|
|
☆
|
|
KroVin 300
|
2-9.5
|
☆
|
☆
|
☆
|
☆
|
|
|
☆
|
|
KroVin 360
|
3-8.5
|
☆
|
☆
|
☆
|
☆
|
☆
|
☆
|
☆
|
|
KroVin 500
|
5-11
|
☆
|
|
|
|
☆
|
☆
|
☆
|
|
KroVin 950
|
2-12
|
☆
|
☆
|
☆
|
☆
|
|
☆
|
|
KroVin?500杀抑菌效果测试与性能比较
一、实验原理
通过KroVin?500等系列工作浓度、接种到易染实验室及仓库等环境试验菌的培养皿,在一定时间培养过程中,随着各抑菌剂从原点向周围的辐射,会有圆形区域无法长出菌苔,从而显示其抑菌作用。实验通过抑菌圈及直径大小判断其抑菌能力。
二、实验用品
85mm 培养皿、离心管、移液器、移液管、生物安全柜、生理盐水、恒温培养箱、无菌纯水、接种环、涂棒、孟加拉红琼脂培养基、大豆胰蛋白培养基等。
三、菌种
取西宝公司实验室、生产车间、仓库、过道的角落和设备处,用无菌棉球蘸取污物,接种到营养肉汤琼脂平板、孟加拉红琼脂平板、马铃薯葡萄糖琼脂平板,32℃培养长出菌落菌苔,挑取平板上易感代表性的菌落加入生理盐水,制成混合菌接种液,接种液麦氏浊度1 左右。
四、抑制剂
KroVin300(下图简称“KV300”,货号:ACN0037B,品牌:Seebio)
KroVin360(下图简称“KV360”,货号:ACN0917A,品牌:Seebio)
KroVin500(下图简称“KV500”,货号:ACN0046A,品牌:Seebio)
Proclin 300(下图简称“P*300”,品牌:进口某Si*a品牌)
KroVin360(下图简称“KV360”,货号:ACN0917A,品牌:Seebio)
KroVin500(下图简称“KV500”,货号:ACN0046A,品牌:Seebio)
Proclin 300(下图简称“P*300”,品牌:进口某Si*a品牌)
五、操作
1、将4 种抑制剂配制成1:250、1:500、1:1000、1:2000 的样品存放2-8 度待用。配制大豆络蛋白和孟加拉红琼脂培养基,各200ml,121℃灭菌15min,洁净
2、生物安全柜内冷却至50℃左右,各加入3ml 接种液,摇晃均匀后浇注平板。
3、如下图在平板上标注样品位置,放置牛津杯,在牛津杯中加入270ul 样品。每个配比两个板。32℃下培养22h 观察记录。

4、设置空白对照板。
六、实验情况
1:250

1:500
1:1000

1:2000

环境中提取的菌


七、观察记录分析
1、1:250 组大豆酪蛋白板
KV300,抑菌圈完整透明整洁,大小约3cm,板1 板2 基本一致。
KV360,抑菌圈基本完整,半透明,边缘与KV500 交叉,圈上有单菌落和绒状物,大小约2.5-3cm,板1 、板2 基本一致。
KV500,抑菌圈基本完整,半透明,边缘与KV360交叉,圈上有单菌落和绒状物,大小约5cm板1、板2 基本一致。
PC300,抑菌圈完整透明整洁,大小约3cm,板1 板2 基本一致。
KV360,抑菌圈基本完整,半透明,边缘与KV500 交叉,圈上有单菌落和绒状物,大小约2.5-3cm,板1 、板2 基本一致。
KV500,抑菌圈基本完整,半透明,边缘与KV360交叉,圈上有单菌落和绒状物,大小约5cm板1、板2 基本一致。
PC300,抑菌圈完整透明整洁,大小约3cm,板1 板2 基本一致。
分析,目测板上微生物主要为细菌及少量曲霉,从抑菌圈大小看,KV500 最好,另外3 种差不多。从抑菌圈的干净度看,KV300 和PC300 最好,目测圈内无微生物,KV500 边缘部分有微生物,KV360 圈内有微生物,分析可能为不能抑制接种液中所有种类的微生物或者是抑制效果弱。
2、1:500 组大豆酪蛋白板
KV300,大小约2.8cm,其他情况同1:250 组。
KV360,大小约2.7cm,其他情况同1:250 组。
KV500,大小约4.2cm,其他情况同1:250 组。
PC300,大小约2.7cm,其他情况同1:250 组。
KV360,大小约2.7cm,其他情况同1:250 组。
KV500,大小约4.2cm,其他情况同1:250 组。
PC300,大小约2.7cm,其他情况同1:250 组。
3、1:1000 组大豆酪蛋白板
KV300,大小约2.5cm,其他情况同1:250 组。
KV360,大小2.1-2.3cm,其他情况同1:250 组。
KV500,大小约4cm,其他情况同1:250 组。
PC300,大小约2.5cm,其他情况同1:250 组。
KV360,大小2.1-2.3cm,其他情况同1:250 组。
KV500,大小约4cm,其他情况同1:250 组。
PC300,大小约2.5cm,其他情况同1:250 组。
4、1:2000 组大豆酪蛋白板
KV300,大小约2cm,其他情况同1:250 组。
KV360,大小月2cm,其他情况同1:250 组。
KV500,大小约3.5cm,其他情况同1:250 组。
PC300,大小约2cm,其他情况同1:250 组。
KV360,大小月2cm,其他情况同1:250 组。
KV500,大小约3.5cm,其他情况同1:250 组。
PC300,大小约2cm,其他情况同1:250 组。
5、1:250 组孟加拉红板
KV360 无抑菌圈,KV300、KV500、PC300 抑菌圈连成片,板1 板2 基本一致。
6、1:500 组孟加拉红板
KV360 无抑菌圈,KV300、KV500、PC300 抑菌圈连成片,目测大小KV300>KV500>PC300。板1、板2基本一致。
7、1:1000 组孟加拉红板
KV360 无抑菌圈,KV300、KV500、PC300 抑菌圈连成片,目测大小差不多,PC300 小一些。板1、板2基本一致。
8、1:2000 组孟加拉红板
KV360 无抑菌圈,KV300、KV500、PC300 抑菌圈连成片,KV300 和KV500 约2.5cm,PC300 小一些,边上有绒状物。板1 板2 基本一致。
八、小结
1、随着稀释倍数的逐步放大,样品的抑菌效果逐步减弱。
2、大豆酪蛋白板,KV500 的圈最大,边缘会有些菌带,说明边缘部分的抑制效果较弱。KV300 和PC300圈没KV500 大,圈内干净无菌落,说明对接种液内的细菌都有较好的抑制效果。
3、K360 对接种液中的曲霉类真菌无效果,KV300、PC300、KV500 效果差不多,PC300 的圈边缘有些菌带,效果弱一些。如配方体系必须用KV360,可与KV500或KV300复配使用,具体以用户试验结果为准。
2、大豆酪蛋白板,KV500 的圈最大,边缘会有些菌带,说明边缘部分的抑制效果较弱。KV300 和PC300圈没KV500 大,圈内干净无菌落,说明对接种液内的细菌都有较好的抑制效果。
3、K360 对接种液中的曲霉类真菌无效果,KV300、PC300、KV500 效果差不多,PC300 的圈边缘有些菌带,效果弱一些。如配方体系必须用KV360,可与KV500或KV300复配使用,具体以用户试验结果为准。


















